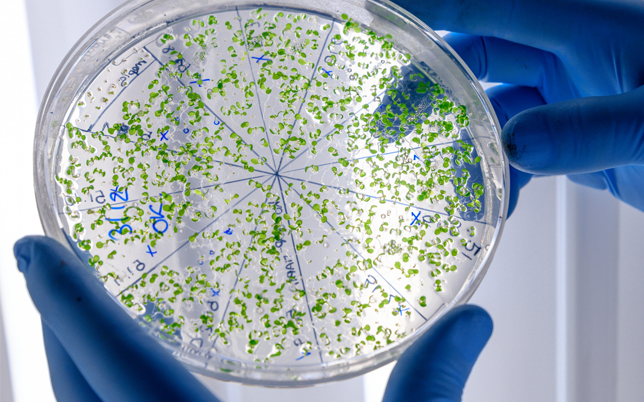

Reutiliza hoy, preserva mañana
Expertos en Tratamiento de Aguas
IR A SERVICIOS

Somos Aguambiente, especialistas en la fabricación, mantención y reparación de plantas de tratamiento de aguas servidas, con el objetivo de reciclar agua para riego, promoviendo soluciones sostenibles frente a la escasez de este recurso. Con un equipo experto de ingenieros y técnicos, ofrecemos diseño, implementación y mantención de sistemas de tratamiento, siempre comprometidos con la normativa y el cuidado del medio ambiente.
Instalamos en…






Servicios
En Aguambiente Spa , nos especializamos en ofrecer soluciones integrales para el tratamiento y mantenimiento de sistemas de aguas servidas, garantizando la eficiencia y sostenibilidad de sus operaciones.
Mantenciones
Operación y mantenimiento de plantas de tratamiento de aguas servidas para asegurar su funcionamiento óptimo.
Reacondicionamiento PTAS
Actualización de plantas de tratamiento antiguas para mejorar su eficiencia sin necesidad de construir nuevas instalaciones.
Análisis de Laboratorio
Servicios de análisis físico-químico, metales pesados, cromatografía y bacteriología en diversas muestras de agua y residuos.
Extracción lodos, grasas y limpieza hidrojet
Limpieza y extracción de residuos en plantas de tratamiento y fosas sépticas utilizando equipos especializados.
Filtro de Carbón Activado
Suministro e instalación de filtros para eliminar olores y contaminantes en sistemas de tratamiento de aguas.
Nuestras plantas de tratamiento…
Consideran los parámetros de Aireación Convencional con utilización de lodos activados.
Cumpliendo con la normativa Nch 1333/78 , DS Nº 90 tabla Nº1 y DS N°46.
Productos
Ofrecemos soluciones avanzadas para el tratamiento y mejora de la calidad del agua, esenciales para afrontar la escasez de este recurso vital. Nuestros productos están diseñados para optimizar el uso del agua, promover su reutilización segura y contribuir a la sostenibilidad ambiental.